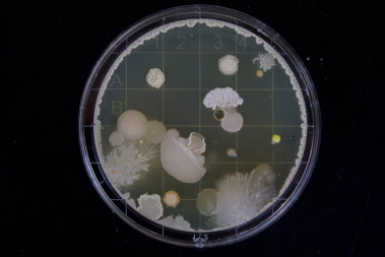

Новый НДС и патент: малый бизнес Приамурья на грани выживания
Рестораторы региона предупреждают о волне закрытий из-за налоговой реформы
21 октября, 19:50
Новый НДС и патент: малый бизнес Приамурья на грани выживания
Рестораторы региона предупреждают о волне закрытий из-за налоговой реформы
21 октября, 19:50
 Украинского шпиона задержала ФСБ в Амурской области
Подозреваемому грозит пожизненный срок
22 октября, 18:03
Украинского шпиона задержала ФСБ в Амурской области
Подозреваемому грозит пожизненный срок
22 октября, 18:03
 Билеты на автобус из Благовещенска в Хэйхэ доступны онлайн
Электронные продажи избавят пассажиров от очередей в кассы
22 октября, 16:41
Билеты на автобус из Благовещенска в Хэйхэ доступны онлайн
Электронные продажи избавят пассажиров от очередей в кассы
22 октября, 16:41
 В Амурской области перевернулся КамАЗ: есть погибший
Тяжелая техника опрокинулась во время буксировки другого транспорта
22 октября, 16:29
В Амурской области перевернулся КамАЗ: есть погибший
Тяжелая техника опрокинулась во время буксировки другого транспорта
22 октября, 16:29
 Конкурс "Мой Дальний" научит молодежь смело делиться своими идеями — Марат Садриев
Предприниматель из Чукотского автономного округа рассказал, как видео-эссе помогает молодым людям проявлять индивидуальность
22 октября, 15:25
Конкурс "Мой Дальний" научит молодежь смело делиться своими идеями — Марат Садриев
Предприниматель из Чукотского автономного округа рассказал, как видео-эссе помогает молодым людям проявлять индивидуальность
22 октября, 15:25
 В Приамурье спасают от потопов загруженную трассу
Финишировал ремонт 7-километрового участка дороги "Благовещенск - Свободный"
22 октября, 15:22
В Приамурье спасают от потопов загруженную трассу
Финишировал ремонт 7-километрового участка дороги "Благовещенск - Свободный"
22 октября, 15:22
 Амурские "творцы" драпируют золотом Китай
Группа "Сигналы" транслирует мысли о вечном
22 октября, 15:06
Амурские "творцы" драпируют золотом Китай
Группа "Сигналы" транслирует мысли о вечном
22 октября, 15:06
 Взятку сотруднику МВД предложил пассажир в аэропорту Благовещенска
Житель Красноярского края хотел "откупиться" от административного протокола
22 октября, 13:37
Взятку сотруднику МВД предложил пассажир в аэропорту Благовещенска
Житель Красноярского края хотел "откупиться" от административного протокола
22 октября, 13:37
 Основы предпринимательской деятельности изучают ветераны СВО в ЕАО
Обучение пройдут более 20 человек
22 октября, 12:20
Основы предпринимательской деятельности изучают ветераны СВО в ЕАО
Обучение пройдут более 20 человек
22 октября, 12:20
 Напавшего с битой на школьницу амурчанина направили к психиатрам
Мужчина ударил битой по голове подростка на улице Благовещенска
22 октября, 12:16
Напавшего с битой на школьницу амурчанина направили к психиатрам
Мужчина ударил битой по голове подростка на улице Благовещенска
22 октября, 12:16
 Десятки птиц спасли от съедения иностранцами в Приамурье
Пернатых, угодивших в браконьерскую сеть, вызволили в Благовещенском округе
22 октября, 11:51
Десятки птиц спасли от съедения иностранцами в Приамурье
Пернатых, угодивших в браконьерскую сеть, вызволили в Благовещенском округе
22 октября, 11:51
 Огромный долг вернул амурчанин после жесткого ультиматума приставов
Арест счетов и ограничения по недвижимости подействовали на должника
22 октября, 11:40
Огромный долг вернул амурчанин после жесткого ультиматума приставов
Арест счетов и ограничения по недвижимости подействовали на должника
22 октября, 11:40
 Год свободы за каждые три грамма: приговор наркосбытчице вынесли в Приамурье
Жительницу Благовещенска взяли под стражу в зале суда
22 октября, 11:14
Год свободы за каждые три грамма: приговор наркосбытчице вынесли в Приамурье
Жительницу Благовещенска взяли под стражу в зале суда
22 октября, 11:14
 Нападение на офицера военной комендатуры расследовали в Благовещенске
Приятель солдата, самовольно покинувшего часть, сбил с ног инспектора
22 октября, 11:03
Нападение на офицера военной комендатуры расследовали в Благовещенске
Приятель солдата, самовольно покинувшего часть, сбил с ног инспектора
22 октября, 11:03
 Прапорщик из Приамурья уничтожил группу боевиков в зоне СВО
Военнослужащий проявил отвагу и профессионализм во время выполнения боевой задачи
22 октября, 10:48
Прапорщик из Приамурья уничтожил группу боевиков в зоне СВО
Военнослужащий проявил отвагу и профессионализм во время выполнения боевой задачи
22 октября, 10:48
От экологии до борьбы с раком: о возможностях ГМ-бактерий рассказали в ПИШ ДВФУ
Пока учёным удаётся культивировать лишь около 15% известных микроорганизмов
22 октября, 10:34
От экологии до борьбы с раком: о возможностях ГМ-бактерий рассказали в ПИШ ДВФУ
Пока учёным удаётся культивировать лишь около 15% известных микроорганизмов
22 октября, 10:34
 Незаконную сделку с землей разоблачили в Амурской области
Суд признал договор купли-продажи участка недействительным
22 октября, 09:47
Незаконную сделку с землей разоблачили в Амурской области
Суд признал договор купли-продажи участка недействительным
22 октября, 09:47
 Роспотребнадзор изъял 6 тонн опасной продукции в Приамурье
Специалисты выявили просрочку, отсутствие маркировки и несоблюдение санитарных норм
22 октября, 09:40
Роспотребнадзор изъял 6 тонн опасной продукции в Приамурье
Специалисты выявили просрочку, отсутствие маркировки и несоблюдение санитарных норм
22 октября, 09:40
 Ты явно не россиянин, если не ответишь на эти простые вопросы - ТЕСТ
Некоторые вопросы способны поставить в тупик даже очень эрудированные люди
22 октября, 09:30
Ты явно не россиянин, если не ответишь на эти простые вопросы - ТЕСТ
Некоторые вопросы способны поставить в тупик даже очень эрудированные люди
22 октября, 09:30
 Село с перспективой: современную школу искусств построят в Приамурье
Инклюзивную площадку для талантов создадут в Серышевском округе
22 октября, 08:13
Село с перспективой: современную школу искусств построят в Приамурье
Инклюзивную площадку для талантов создадут в Серышевском округе
22 октября, 08:13